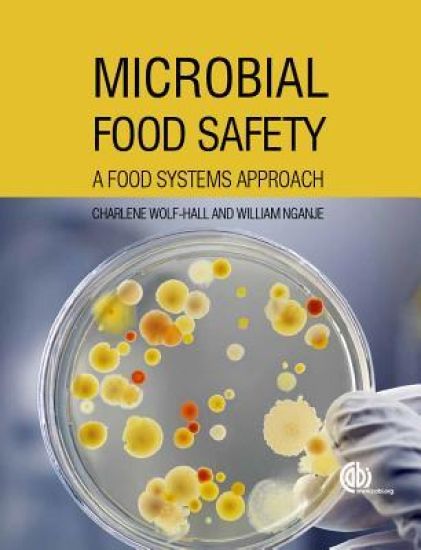
Microbial Food Safety

Maya's WorldCooking is an art, and art knows no bounds of age. The "ABC's of Cooking" in Maya's World is a whirlwind adventure revolving around all things food and takes place in the most important place of them all - the kitchen. Maya - the Little Chef Six year old Maya is an inquisitive child of a food blogger. Having always seen her mother conjure up delicacies and critique numerous dishes, Maya grew fond of the world of food. This natural inclination turned into a hobby as this little one transformed into the MasterChef of the house, playing away at kitchen equipment, learning cooking techniques, and of course, creating loads of mess in the process From A to Z: Learn it All Little chef turned cooking teacher; the ABC's of Cooking will teach all budding chefs (as young as 4-year-olds ) to cook magic in the kitchen Beginning with How to Wear and Apron, the book runs through How to Use Kitchen Gadgets, How to Create Simple Delicacies, and beyond.Post reading, you will know how to: - Fry - Grill- Infuse- Velvet- Zest a lime- Use a ladle and whisk and a lot more Simple Illustrations for Easy CookingExpect a lot of funny, yet realistic illustrations in Maya's World for a thorough learning experience. What Maya learnt from her mother, is what she intends to impart to her young readers in this book - to make everybody a Foodie